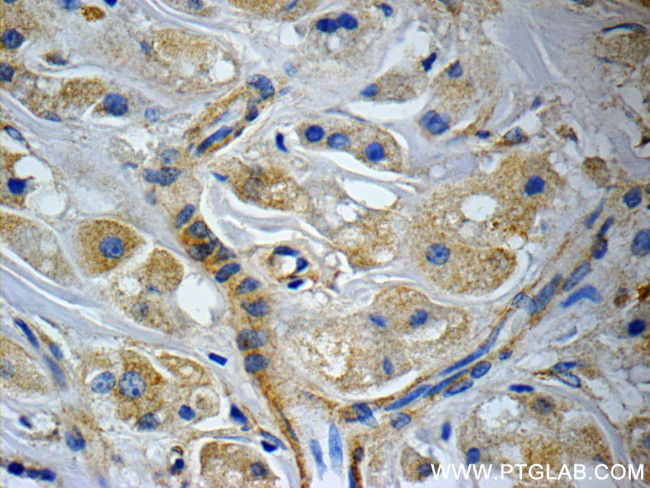
CCDC53 Antibody in Immunohistochemistry (Paraffin) (IHC (P))

Search
Proteintech
CCDC53 Polyclonal Antibody
{{$productOrderCtrl.translations['antibody.pdp.commerceCard.promotion.promotions']}}
{{$productOrderCtrl.translations['antibody.pdp.commerceCard.promotion.viewpromo']}}
{{$productOrderCtrl.translations['antibody.pdp.commerceCard.promotion.promocode']}}: {{promo.promoCode}} {{promo.promoTitle}} {{promo.promoDescription}}. {{$productOrderCtrl.translations['antibody.pdp.commerceCard.promotion.learnmore']}}
产品信息
24445-1-AP
种属反应
已发表种属
宿主/亚型
分类
类型
抗原
偶联物
形式
浓度
规格
纯化类型
保存液
内含物
保存条件
运输条件
产品详细信息
Immunogen sequence: MDEDGLPLM GSGIDLTKVP AIQQKRTVAF LNQFVVHTVQ FLNRFSTVCE EKLADLSLRI QQIETTLNIL DAKLSSIPGL DDVTVEVSPL NVTSVTNGAH PEATSEQPQQ SSTQDSGLQE SEVSAENILT VAKDPRYARY LKMVQVGVPV MAIRNKMISE GLDPDLLERP DAPVPDGESE KTVEESSDSE SSFSD (1-194 aa encoded by BC010889)
靶标信息
Acts as a component of the WASH core complex that functions as a nucleation-promoting factor (NPF) at the surface of endosomes, where it recruits and activates the Arp2/3 complex to induce actin polymerization, playing a key role in the fission of tubules that serve as transport intermediates during endosome sorting. [UniProt]
仅用于科研。不用于诊断过程。未经明确授权不得转售。
生物信息学
蛋白别名: AD-016; CGI-116; coiled-coil domain containing 53; Coiled-coil domain-containing protein 53; unnamed protein product; WASH complex subunit 3; WASH complex subunit CCDC53
基因别名: AD-016; CCDC53; CGI-116; WASHC3; x0009
UniProt ID: (Human) Q9Y3C0
Entrez Gene ID: (Human) 51019